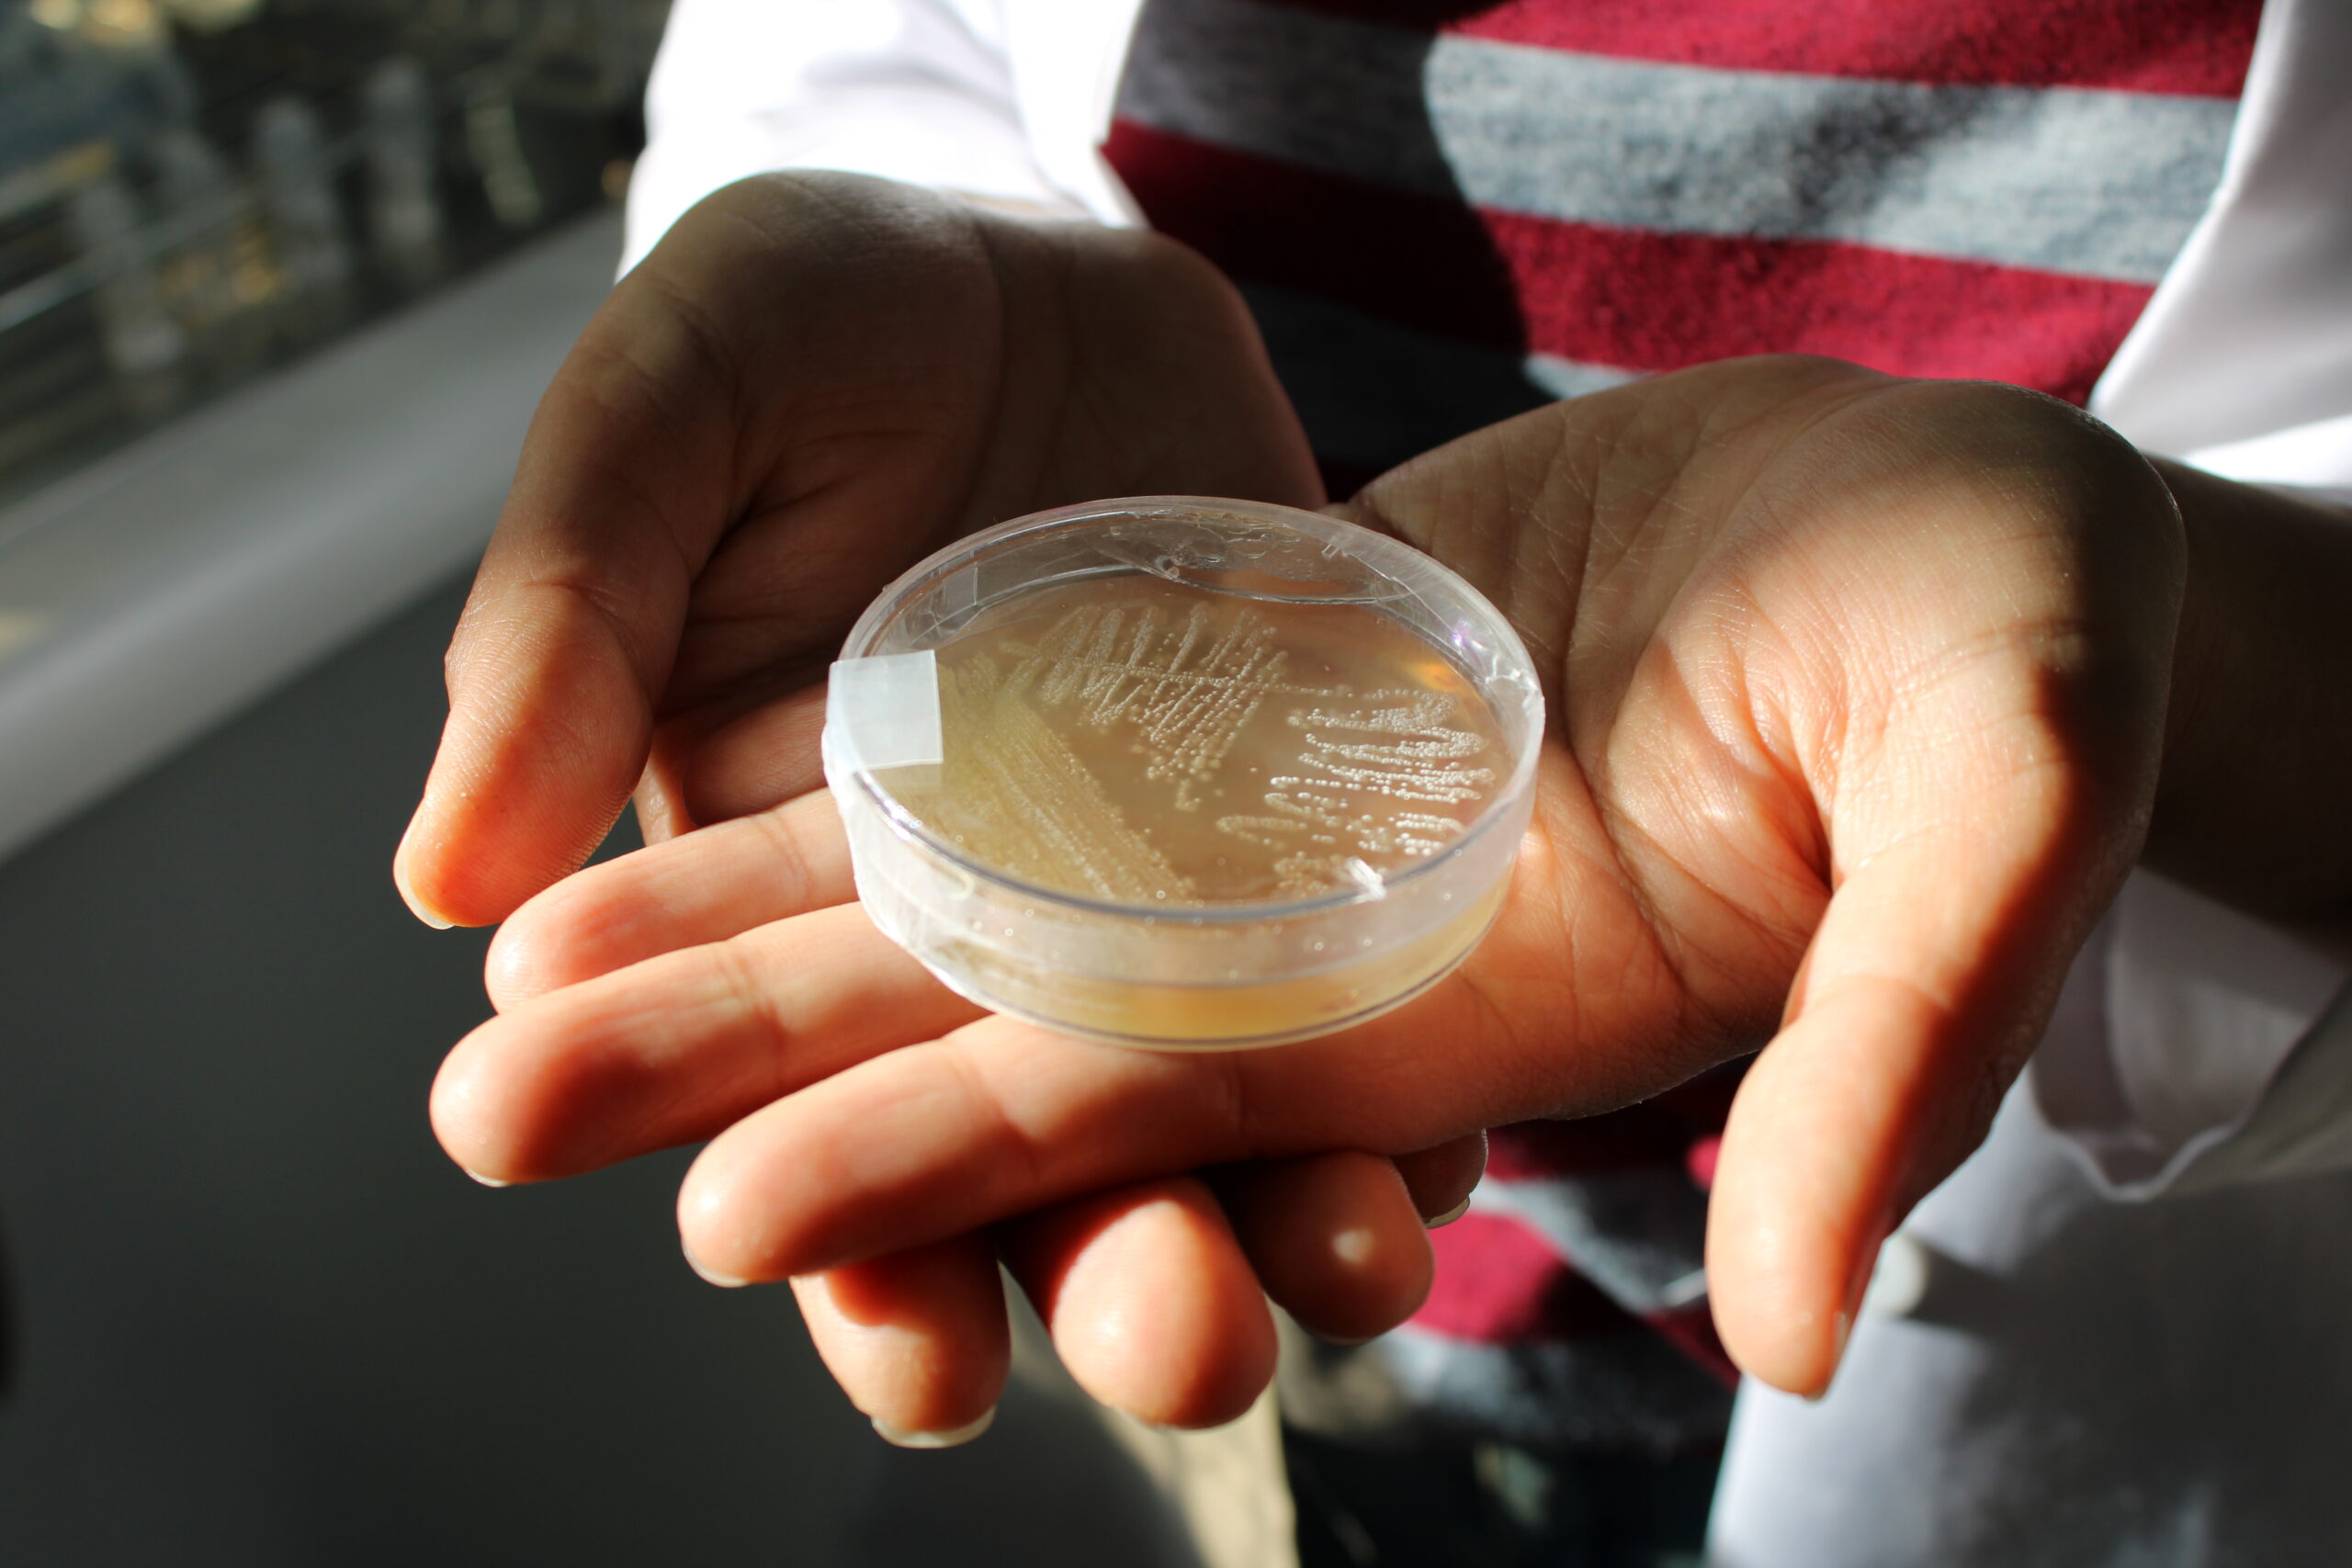

La doctora en ciencias e investigadora del Centro de Biotecnología “Dr. Daniel Alkalay Lowitt”,de la Universidad de Vala, Fernanda Claverías, se encuentra investigando un grupo bacteriano en la playa Las Torpederas de Valparaíso que podría derivar en la creación de nuevos antibióticos con aplicación en humanos.
La curiosidad del grupo de bacterias “Actinomycetotas” comenzó hace varios años y su trabajo le ha permitido descubrir una nueva especie de bacterias a la cual denominó “Spiractinospora alimapuensis”. La experta señala que “la mayoría de los antibióticos de origen bacteriano que utilizamos hoy para salud humana provienen de las Actinomycetotas que producen este tipo de compuestos”.
Aunque no se puede asegurar que esta bacteria marina no exista en otra parte, no hay registros de que haya sido aislada en otro lugar del mundo. El trabajo de la investigadora, por tanto, ha sido descifrar cuáles son las adaptaciones ambientales para que este tipo de bacterias se propague específicamente en Valparaíso, dado que es “una bacteria alcalófila y halotolerante. Eso quiere decir que les gustan más las condiciones de pH alcalino y no ácido. Puede crecer sin sal, pero crece mejor en condiciones con mayor salinidad. Y eso también nos da una pista de que probablemente está muy adaptada al medio marino porque el mar es ligeramente alcalino”.
Descifrando el genoma
La investigadora explica que las proyecciones son conocer la genética de esta bacteria y realizar los cultivos para ver si hay algún componente antibiótico. “Nosotros hacemos el análisis del genoma para ver si producen compuestos que pueden ser bioactivos o antibióticos en este caso”.
De esta forma, se predice si existe o no un nuevo compuesto que tenga este potencial antibiótico. “En el caso de mi investigación, en esta bacteria no he encontrado ningún antibiótico conocido, sin embargo, lo que podido ver a través de la bioinformática son potenciales compuestos que tendrían modificaciones muy interesantes en los cuales me estoy enfocando para ver si, efectivamente, hay actividad antimicrobiana, o incluso, antitumoral”, explica Claverías. Una vez finalizado este trabajo se puede ver su viabilidad y aplicación en humanos dada la alta demanda de nuevos antibióticos debido a la creciente resistencia que se ha generado